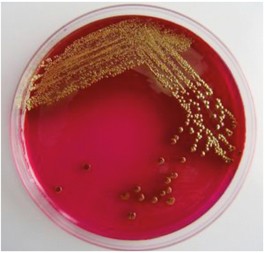

Higiena: Escherichia coli w zakładzie mleczarskim
Mleko i produkty mleczne
Mleko i produkty mleczne były badane przez wszystkie kraje członkowskie. Większość wykrytych pozytywnych próbek dotyczyła surowego mleka krowiego, w Belgii było to 2,6%. W Niemczech E. coli znaleziono w 1,1% takiego mleka, a ponadto w 5,3% próbek w mleku surowym w sprzedaży detalicznej oraz 3,8% w mleku przeznaczonym do produkcji wyrobów pasteryzowanych. Żadna z badanych próbek nie była VTEC O157 – pozytywna.
Badaniu poddano również sery świeże, miękkie i półmiękkie z mleka surowego lub poddanego obróbce cieplnej w niskich temperaturach w gospodarstwach przetwarzania i sprzedaży detalicznej – bakterii VTEC nie znaleziono. W sprzedaży detalicznej w Niemczech znaleziono tylko jedną próbkę dodatnią VTEC – w twardych serach z mleka pasteryzowanego. Włochy znalazły w 5,9% badanych próbek serów VTEC, ale żadna z nich nie była VTEC O157.
Inne badane przez kraje członkowskie UE produkty mleczne w 2011 r., to: głównie masło i śmietana produkowane z mleka surowego lub mleka poddanego obróbce cieplnej w niskich temperaturach. W Belgii nie stwierdzono obecności w badanych próbkach VTEC. Włochy do raportu EFSA podały wyniki badań masła, gdzie w 4,4% wykrywano VTEC i 0,9% VTEC O157.
VTEC była wykrywana też w próbkach mleka od innych ssaków.
Escherichia należy do rodziny Enterobacteriaceae. Szczegółowo systematykę oraz gatunki i serotypy E. coli pokazano w tabeli 2.

Ma kształt pałeczki – stąd polska nazwa bakterii – pałeczka okrężnicy. Nazwa wskazuje na naturalne miejsce bytowania drobnoustroju – jelita zwierząt i człowieka – stanowi tam naturalną mikroflorę, która jak się szacuje odpowiada za 60-70% produkcji witamin z grupy B i K z błonnika pokarmowego. Bakteria jest wszechobecna – w wodzie i w glebie, gdzie trafia z wydalinami zwierząt. Zatem miano Coli jest często stosowanym wskaźnikiem zanieczyszczenia środowiskowego.
Bakterie E. coli mogą kolonizować oprócz jelit również skórę i błony śluzowe jamy ustnej oraz układu oddechowego. Mogą powodować biegunki, zakażenia dróg moczowych, zakażenia płuc, a nawet układu nerwowego.
Morfologia bakterii
E. coli jest krótką, grubą, ruchomą lub nieruchomą pałeczką o wym. 1-1,5x2,0-6,0 µm. Gatunek E. coli dzieli się na serotypy na podstawie zróżnicowania budowy antygenów. Szczepy bakterii różnicuje się na podstawie cech antygenowych takich jak: antygen somatyczny O, antygen powierzchniowy K, antygen rzęskowy H. Wyróżnia się 171 antygenów O, około 80 antygenów K i ponad 50 antygenów H, dzięki którym wyszczególnione ponad 180 typów serologicznych tego drobnoustroju. W przypadku szczepów E. coli posiadających wielocukrową otoczkę – antygen otoczkowy K jest również uwzględniany w klasyfikacji np.: szczepy E. coli posiadające antygen K1 są często izolowane z przypadków zapalenia opon mózgowo-rdzeniowych noworodków.
E. coli zazwyczaj rośnie na zwykłych podłożach w temperaturze 20-40°C. Na bulionie tworzy jednolite zmętnienie. Jest bakterią gazującą, co wykorzystywane jest przy oznaczaniu miana coli – wytwarza kwas i gaz, z cukrów takich jak laktoza, maltoza oraz innych.
Wytrzymałość E. coli na czynniki środowiskowe jest stosunkowo mała. Ginie ona po 20 minutach ogrzewania w temperaturze 60°C, wrażliwa jest na wszystkie znane środki dezynfekcyjne. Jednakże w środowisku o temp. niższej i odpowiedniej wilgotności utrzymuje się miesiącami. W kale o temp. 0°C może zachować żywotność ponad rok.
Szczepy toksynotwórcze produkują w jelitach duże ilości toksyn, prowadząc do enterotoksemii. Enterotoksyna działając na śluzówkę jelit w połączeniu z endotoksyną powoduje zapalenie jelit i objawy zatrucia. Neurotoksyna wchłonięta do organizmu z przewodu pokarmowego, prowadzi do wystąpienia charakterystycznych objawów ze strony układu nerwowego oraz przyczynia się do powstania chorób, np. choroby obrzękowej u świń. Szczepy hemolityczne są bardziej chorobotwórcze niż szczepy niehemolityczne. Hemolizyna ma bowiem właściwości toksyny o działaniu nie tylko hemolitycznym, ale także dermonekrotycznym i koagulującym plazmę.
Wzrost E. coli na podłożu VRBGagar
Źródło: www.freepik.com – pobranie 15.12.2013

E. coli – zdjęcie z mikroskopu elektronowego – powiększenie ok. 10000x
Źródło: www.gronkowiec.pl, pobranie 20.11.2013 r.
Epidemiologia
Bakteria u dzieci może powodować biegunki i zapalenie opon mózgowo-rdzeniowych, u dorosłych zapalenie układu moczowo-płciowego (w tym zapalenie i cysty jajników, problemy z prostatą), zapalenie otrzewnej, zapalenie pęcherzyka żółciowego, zakażenie ran zanieczyszczonych kałem, ropne zapalenie nerek, biegunki.
Źródłem zakażenia jest człowiek oraz zwierzęta będące nosicielami szczepów chorobotwórczych dla ludzi. Do zakażenia Escherichia coli dochodzi zwykle w gorących, egzotycznych krajach, takich jak kraje afrykańskie np. Egipt, kraje azjatyckie np. Indie czy Tajlandia, kraje Ameryki np. Meksyk a szczególnie Ameryki Środkowej i Południowej tj.: Panama, Wenezuela, Brazylia itp. Wywołana tą bakterią biegunka, nazywana jest tropikalną lub brzuchem Delphi, albo zemstą Montezumy.
Escherichia coli można także zarazić się jedząc surowe warzywa i owoce lub pijąc nieprzegotowana wodę. Objawy występują już po 12-72 godzinach od zakażenia, a są to wymioty, biegunka oraz kurczowe bóle brzucha. Zazwyczaj trwają przez około 10 dni. Najważniejsze wtedy, by nie dopuścić do odwodnienia organizmu.
Na podstawie przedstawionych danych epidemiologicznych oraz związanych bezpośrednio z zatruciami pokarmowymi wyraźnie widać, że rezerwuarem zarazka jest przewód pokarmowy bydła oraz brak należytej higieny pracowników pracujących przy hodowli zwierząt – tylko tak można tłumaczyć obecność E. coli na sierści zwierząt i jej brak w przewodzie pokarmowym. Należyta czystość wody pitnej, odpowiednie nawyki higieniczne pracowników pracujących w całym łańcuchu żywnościowym „od pola do stołu” w tym w przemyśle spożywczym oraz na kolejnych etapach dystrybucji i obrotu żywnością są szczególnie istotne jeśli chodzi o zapobieganie epidemiom odpokarmowym. Eschericha coli jest „przyjacielem” człowieka bytującym w jelicie grubym, ale ze względu na potencjalnie wirulentne szczepy i poważne konsekwencje zachorowań należy dbać o odpowiednia higienę miejsc pracy i pracownika.
Bibliografia do wiadomości redakcji.



